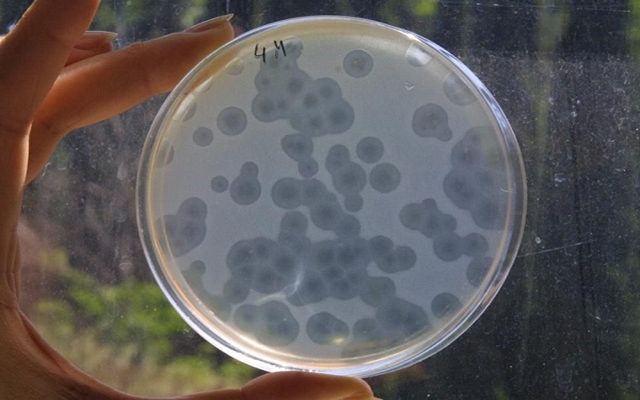

دراسة : جينات ” ميكروباتنا ” أكثر من نجوم الكون !
في دراسة هي الأولى من نوعها، اكتشف باحثون أميركيون أن الميكروبيوم البشري ربما يحتوي على جينات يزيد عددها بالفعل عن عدد النجوم الموجودة في الكون !
وقام الباحثون في تلك الدراسة التي أجروها بكلية طب جامعة هارفارد بتجميع 3500 عينة من الميكروبيوم البشري (مجموع الكائنات الحية الدقيقة التي تتعايش مع الإنسان) من الفم والأمعاء، وفق ما ذكرت صحيفة “إيلاف”، وبينما وضع تقيم للباحثين عدد الجينات عند رقم 232 مليون جين، فقد قارنها تقييم آخر بعدد الذرات الموجودة في الكون، كناية عن كثرتها، ومن المثير للدهشة أن نصف الجينات المكتشفة بدت فريدة بالنسبة للفرد.
وقال الباحثون في نفس الوقت إن النتائج التي توصلوا إليها لا يمكنها أن توفر أدلة حول الأثر البيئي أو خطر الإصابة بالأمراض فحسب، بل تقود كذلك لعلاجات تفيد الناس بناءً على التركيبة الميكروبية الوراثية، بدلاً من نوع البكتيريا الموجودة لديهم.
وتشير تقديرات إلى أن ذلك الميكروبيوم البشري – وهي البكتيريا التي تعيش في أنوفنا، أفواهنا، أمعائنا وأماكن أخرى – يحتوي على تريليونات من الأنواع البكتيرية.
وفي حين أن معظم هذه البكتيريا غير ضار، حيث يفيد بعضها حتى في تعزيز المناعة، مكافحة نمو الأورام الخبيثة، تحسين الهضم وخفض الكولسترول، فإن هناك أنواع منها ضارة، وتتسبب في حدوث عدوى والتهابات بالأسنان، الجلد والأنسجة.
وبينما سبق أن ركز الباحثون في معظم دراساتهم التي أجروها من قبل على تحديد أنواع مختلفة من البكتيريا، لمعرفة الطريقة التي تؤثر بها على صحتنا، فقد نقلت صحيفة “دايلي ميل” البريطانية، عن برادين تيرني، طالب الدراسات العليا في كلية الطب بجامعة هارفارد والباحث الرئيسي بتلك الدراسة الجديدة، قوله :”دراستنا هذه عبارة عن بوابة، وهي الخطوة الأولى فيما أتصور أنها ستكون رحلة طويلة نحو فهم كيف أن الاختلاف في محتوى الجينات يؤثر في السلوك الميكروبي ويُعَدِّل خطر المرض”.